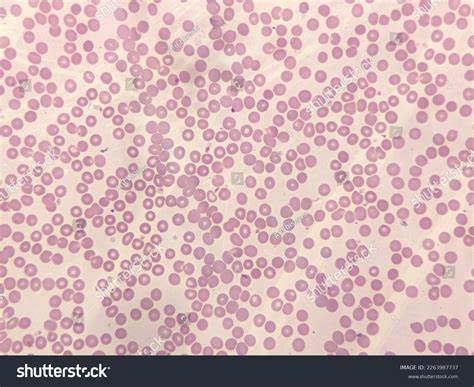

Signs And Symptoms Of Kidney Cancer
What are the main symptoms of kidney cancer?
References
Useful resources and Supporting images
Mayo Clinic: Signs and symptoms of Kidney Cancer
Supporting images: Polycythaemia, Anaemia, Erythropoetin and Haematuria
Updated April 2025 Next Review March 2027

Leave a comment